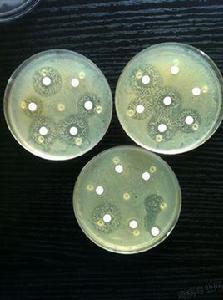
抑菌圈 抑菌圈

定義
抑菌圈抑菌圈(Zone of inhibition)是福萊明發現青黴素的過程中,提出的一個辭彙。他發現,接種了青黴的培養皿中,青黴的周圍不生長細菌,而在遠離青黴的地方有細菌生長。不生長細菌的地方,是一個以青黴菌落為圓心的一個規則的圓,這個圓圈被福萊明稱為抑菌圈。
後來,福萊明發現,這個抑菌圈的出現與青黴分泌的青黴素有關,青黴素有殺菌的作用,將青黴周圍一定範圍內的細菌全部殺死,所以形成了一個以青黴為圓心的沒有細菌生長的抑菌圈。
單位
抑菌圈直徑大小以 mm 作為計量單位。
行業專用儀器
| 行業專用儀器是對於某種行業專用科學儀器設備進行研究開發出來的專用配置儀器。例如:藥物檢測專用儀器、石油產品專用分析儀器、農業和食品專用儀器、紡織...等等。 |